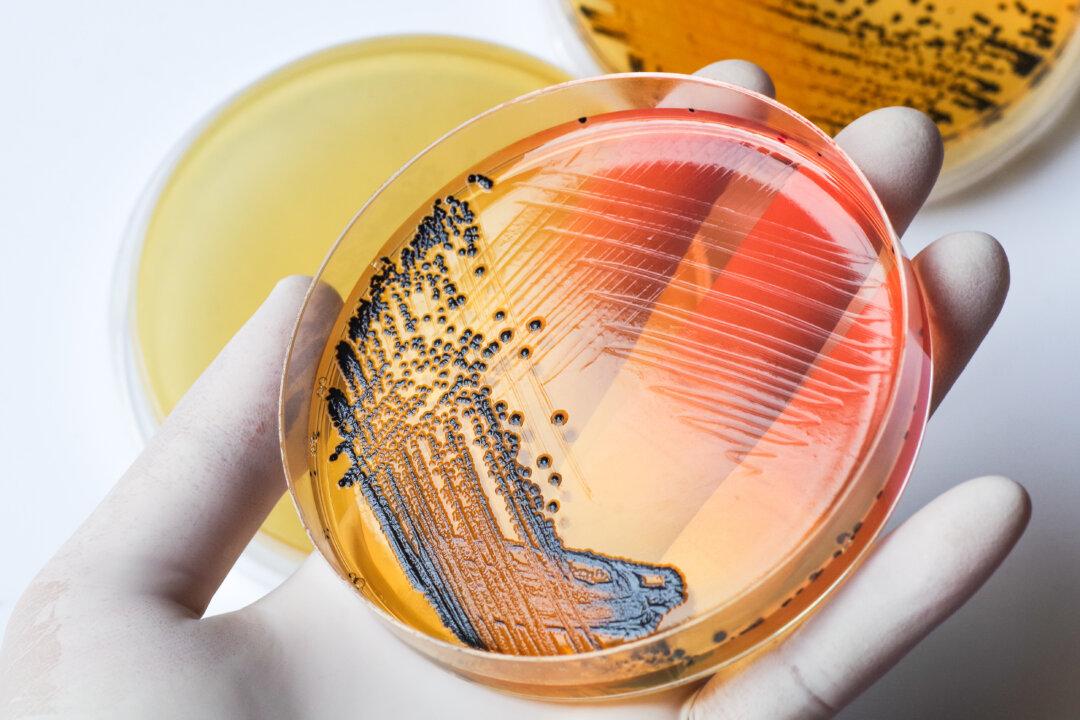
Lack of Urgency in Creating New Antibiotics Raises Concerns

Scientists are warning that despite new antibiotics being developed, there is still a growing global crisis of antibiotic resistance.
A new report from Professor Mark Blaskovich from the Centre for Superbug Solutions at the University of Queensland’s Institute for Molecular Bioscience which assessed the need for developing new antibacterial drugs for the treatment of the increasing drug-resistant bacterial infections, has found that despite there being 62 new antibiotics are currently in development, only 34 of them were not based on structures used for antibiotics before.